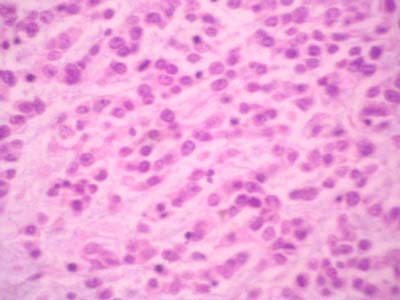

Direccion de contacto
fiogf49gjkf0d Dra Alicia Córdoba
E-mail: ANATPATO@CFNAVARRA.ES
|
|
CARCINOMA METAPLÁSICO DE MAMA VARIANTE " PRODUCTOR DE MATRIZ ". Expresión de CD99 y P63
ALICIA CORDOBA ITURRIAGAGOITIA*, PEDRO de LLANO VARELA*, MARÍA ASUNCIÓN ARRECHEA IRIGOYEN*, RAQUEL BELOQUI PÉREZ*, MARIA LUISA GÓMEZ DORRONSORO*, JOSÉ MARIA MARTÍNEZ-PEÑUELA VÍRSEDA**
* SERVICIO DE ANATOMÍA PATOLÓGICA.
HOSPITAL DE NAVARRA ESPAÑA
** SERVICIO DE ANATOMÍA PATOLÓGICA.
HOSPITAL DE NAVARRA ESPAÑA
|
|
|
Resumen
fiogf49gjkf0d INTRODUCCIÓN:
El carcinoma metaplásico de mama es un grupo heterogéneo de neoplasias, como se traduce en la gran cantidad de términos que se utilizan como: carcinosarcoma, carcinoma sarcomatoide, carcinoma de células fusiformes. La histogénesis de este tumor es desconocida. Ultimamente se ha planteado el posible origen mioepitelial para los carcinomas metaplásicos sin diferenciación escamosa.
MATERIAL Y MÉTODO:
Presentamos el caso de una mujer de 85 años que presenta una gran masa de 4,7 cm en localización retroareolar. Macroscópicamente se trata de una masa blanquecina, de aspecto gelatinoso, blando de contorno lobulado, que corresponde a un tumor con múltiples patrones celulares. El tumor muestra varios focos de carcinoma ductal infiltrante, aunque el componente más abundante es de células pequeñas redondeadas con tendencia a la formación de hileras o cordones inmersas en un estroma basófilo, mixoide.
RESULTADOS:
El estudio inmunohistoquímico muestra que las células pequeñas son positivos para CAM 5,2, S-100, vimentina, P63, y CD99. Las mismas células son negativas para actina y miogenina. El componente epitelial no expresa receptores de estrógeno, ni cerbB2, y es positivo con E-cadherina , P53 y Ki-67. Se trata de un carcinoma metaplásico de mama variante productor de matriz. En este caso hemos podido comprobar que expresa varios marcadores mioepiteliales con lo que corrobora su probable origen mioepitelial.
CONCLUSIONES:
· El carcinoma metaplásico de mama variante productor de matriz resulta positivo para CD99., y es el único subtipo de carcinoma de mama que lo expresa .
· La expresión de varios marcadores mioepitelilales refuerza la teoria de su probabble naturaleza mioepitelilal.
|
|
|
Introduccion
fiogf49gjkf0d
- En general los tumores de mama se derivan del epitelio glandular mamario generando adenocarcinomas. Pero en un 5% de los casos el epitelio carcinomatoso adquiere un patrón de crecimiento no-glandular, denominado metaplásico.
- El carcinoma metaplásico de mama se ha descrito bajo múltiples términos como: carcinosarcoma, carcinoma sarcomatoide, carcinoma de células fusiformes; que se debe en parte a la gran heterogeneidad de este tumor.
- La metaplasia presente en los carcinomas de mama se puede dividir en:
- Homóloga: escamosa y de células fusiformes.
- Heteróloga: ósea , cartilaginosa , etc.
- El carcinoma metaplásico variante productor de matriz, es una variante heteróloga que se caracteriza por un carcinoma con transición directa a un estroma con matriz ósea o cartilaginosa, sin una zona de transición de células fusiformes, ni osteoclastos.
|
|
|
Material y Métodos
fiogf49gjkf0d
- Presentamos el caso de una mujer de 85 años que presenta una gran masa de 4,7 cm en localización retroareolar. Macroscópicamente se trata de una masa blanquecina, de aspecto gelatinoso, blando de contorno lobulado.
- Histológicamente corresponde a un tumor con múltiples patrones celulares. Muestra varios focos de carcinoma ductal infiltrante, aunque el componente más abundante es de células pequeñas redondeadas con tendencia a la formación de hileras o cordones inmersas en un estroma basófilo, mixoide. Se aprecian focos de sarcoma de alto grado tipo histiocitoma fibroso maligno.
- DIAGNÓSTICO: CARCINOMA METAPLÁSICO DE MAMA VARIANTE " PRODUCTOR DE MATRIZ "
 fiogf49gjkf0dFigura 1: Áreas de carcinoma ductal infiltrnte de grado III"> fiogf49gjkf0dFigura 1: Áreas de carcinoma ductal infiltrnte de grado III">
Figura 1 - fiogf49gjkf0d Figura 1: Áreas de carcinoma ductal infiltrnte de grado III
 fiogf49gjkf0dFigura 2: El tumor muestra áreas de sarcoma de alto grado, semejante a un histiocitoma fibroso maligno."> fiogf49gjkf0dFigura 2: El tumor muestra áreas de sarcoma de alto grado, semejante a un histiocitoma fibroso maligno.">
Figura 2 - fiogf49gjkf0d Figura 2: El tumor muestra áreas de sarcoma de alto grado, semejante a un histiocitoma fibroso maligno.
 fiogf49gjkf0dFigura 3: El componente mayoritario de la lesión que presentamos es de células pequeñas y redondas que forman hileras y cordones"> fiogf49gjkf0dFigura 3: El componente mayoritario de la lesión que presentamos es de células pequeñas y redondas que forman hileras y cordones">
Figura 3 - fiogf49gjkf0d Figura 3: El componente mayoritario de la lesión que presentamos es de células pequeñas y redondas que forman hileras y cordones
 fiogf49gjkf0dFigura 4: Estas células se encuentran inmersas en un estroma basófilo. La transición entre el componente epitelial y sarcomatoide es abrupta, sin componente fusocelular intermedio."> fiogf49gjkf0dFigura 4: Estas células se encuentran inmersas en un estroma basófilo. La transición entre el componente epitelial y sarcomatoide es abrupta, sin componente fusocelular intermedio.">
Figura 4 - fiogf49gjkf0d Figura 4: Estas células se encuentran inmersas en un estroma basófilo. La transición entre el componente epitelial y sarcomatoide es abrupta, sin componente fusocelular intermedio.
|
|
|
Resultados
fiogf49gjkf0d
RESULTADO DEL ESTUDIO INMUNOHISTOQUÍMICO
| |
S-100 |
CD99 |
VIM |
P63 |
MYOGEN |
CAM |
ACTINA |
Ki-67 |
ESTROGEN |
PROGEST |
CerbB2 |
CD10 |
E-CADHERINA |
|
C.DUCTAL |
+ |
- |
- |
+ |
- |
+ |
- |
+ |
- |
+ |
- |
- |
+ |
|
COMPONENTE METAPLÁSICO |
+ |
+ |
+ |
+ |
- |
-/+ |
- |
+ |
- |
+ |
- |
- |
- |
 fiogf49gjkf0dFigura 5: El componente sarcomatoide resulta positivo con S-100."> fiogf49gjkf0dFigura 5: El componente sarcomatoide resulta positivo con S-100.">
Figura 5 - fiogf49gjkf0d Figura 5: El componente sarcomatoide resulta positivo con S-100.
 fiogf49gjkf0dFigura 6: Así mismo, las células redondeadas son positivas con vimentina, que resulta negativo en el componente epitelial."> fiogf49gjkf0dFigura 6: Así mismo, las células redondeadas son positivas con vimentina, que resulta negativo en el componente epitelial.">
Figura 6 - fiogf49gjkf0d Figura 6: Así mismo, las células redondeadas son positivas con vimentina, que resulta negativo en el componente epitelial.
 fiogf49gjkf0dFigura 7: Se evidencia una positividad de membrana en el componente sarcomatoide para CD-99, que es exclusivo de este tipo de carcinoma de mama."> fiogf49gjkf0dFigura 7: Se evidencia una positividad de membrana en el componente sarcomatoide para CD-99, que es exclusivo de este tipo de carcinoma de mama.">
Figura 7 - fiogf49gjkf0d Figura 7: Se evidencia una positividad de membrana en el componente sarcomatoide para CD-99, que es exclusivo de este tipo de carcinoma de mama.
 fiogf49gjkf0dFigura 8: El marcador mioepitelial p63 es positivo en el componente de carcinoma ductal infiltrante."> fiogf49gjkf0dFigura 8: El marcador mioepitelial p63 es positivo en el componente de carcinoma ductal infiltrante.">
Figura 8 - fiogf49gjkf0d Figura 8: El marcador mioepitelial p63 es positivo en el componente de carcinoma ductal infiltrante.
 fiogf49gjkf0dFigura 9: La positividad para p63 es positivo en el componente sarcomatoide, mientras que aislada y débil en los cordones epiteliales."> fiogf49gjkf0dFigura 9: La positividad para p63 es positivo en el componente sarcomatoide, mientras que aislada y débil en los cordones epiteliales.">
Figura 9 - fiogf49gjkf0d Figura 9: La positividad para p63 es positivo en el componente sarcomatoide, mientras que aislada y débil en los cordones epiteliales.
|
|
|
Conclusiones
fiogf49gjkf0d
- El carcinoma metaplásico variante productor de matriz resulta positivo para CD99., y es el único subtipo de carcinoma de mama que lo expresa. Este hecho puede ser útil para su identificación en las metástasis.
- La positividad para P63 es exclusiva del carcinoma metaplásico, y resulta negativo en el resto de tumores de mama de patrón sarcomatoide (tumor phillodes y sarcomas primarios de mama).
- La expresión de varios marcadores mioepiteliales refuerza la teoría de su probable naturaleza mioepitelial del componente sarcomatoide del carcinoma metaplásico variante productor de matriz.
- El carcinoma metaplásico variante productor de matriz debe considerarse como un carcinoma de mama (en nuestro caso ductal) con diferenciación mioepitelial.
|
|
|
Bibliografía
- Leibl S, M Gogg-Kammerer, A Sommersacher, H Denk, F Moinfar. Metaplastic breast carcinoma: are they of myoepithelial differentiation? Immunohistochemical profile of the sarcomatoid subtype using novel myoepithelial markers. Am J Surg Pathol 2005;29:347-353.
- N K Popnikolov, AG Ayala, K Graves, Z Gatalica. Benign myopithelial tumors of the breast have immunophenotypic caharacteristics similar to metaplastic matrix-producing and spindle cell carcinomas. Am J Clin Pathol 2003; 120: 161-167.
- MM Koker , CG Kleer. P63 expression in breast cancer. A highly sensitive and specific marker of metaplastic carcinoma. Am J Surg pathol 2004:28:1506-1517.
- H Gobbi, SJ Olson, JF Simpson. Spindle cell metaplastic tumors of the breast (SCMTB) co-express p63, a novel myoepithelial marker, and epithelial markers. Mod Pathol 2004; 17(suppl1):31ª.
- F Millanezi, EM Pereira, FV Ferreira, D Leitao, FC Schmitt. CD 99/MIC-2 surface protein expression in breast carcinomas. Histopathol 2001;39; 578-583.
|
|
|
Comentarios
- Emilio Mayayo Artal (06/10/2005 20:41:09)
Interesante caso. Me apunto lo de la P63 de ahora en adelante. Enhorabuena al equipo.
- Julia Cecilia Cruz Mojarrieta (25/10/2005 10:56:55)
Felicitaciones, caso muy interesante.
- LUIS ALBERTO POLO GARCIA (26/10/2005 16:53:10)
Un trabajo conciso y didactico, desconocia la existencia del P63. Felicitaciones!
|
|
|
|
|


 fiogf49gjkf0dFigura 1: Áreas de carcinoma ductal infiltrnte de grado III">
fiogf49gjkf0dFigura 1: Áreas de carcinoma ductal infiltrnte de grado III">
 fiogf49gjkf0dFigura 2: El tumor muestra áreas de sarcoma de alto grado, semejante a un histiocitoma fibroso maligno.">
fiogf49gjkf0dFigura 2: El tumor muestra áreas de sarcoma de alto grado, semejante a un histiocitoma fibroso maligno.">
fiogf49gjkf0dFigura 3: El componente mayoritario de la lesión que presentamos es de células pequeñas y redondas que forman hileras y cordones">
fiogf49gjkf0dFigura 3: El componente mayoritario de la lesión que presentamos es de células pequeñas y redondas que forman hileras y cordones">
 fiogf49gjkf0dFigura 4: Estas células se encuentran inmersas en un estroma basófilo. La transición entre el componente epitelial y sarcomatoide es abrupta, sin componente fusocelular intermedio.">
fiogf49gjkf0dFigura 4: Estas células se encuentran inmersas en un estroma basófilo. La transición entre el componente epitelial y sarcomatoide es abrupta, sin componente fusocelular intermedio.">
 fiogf49gjkf0dFigura 5: El componente sarcomatoide resulta positivo con S-100.">
fiogf49gjkf0dFigura 5: El componente sarcomatoide resulta positivo con S-100.">
 fiogf49gjkf0dFigura 6: Así mismo, las células redondeadas son positivas con vimentina, que resulta negativo en el componente epitelial.">
fiogf49gjkf0dFigura 6: Así mismo, las células redondeadas son positivas con vimentina, que resulta negativo en el componente epitelial.">
 fiogf49gjkf0dFigura 7: Se evidencia una positividad de membrana en el componente sarcomatoide para CD-99, que es exclusivo de este tipo de carcinoma de mama.">
fiogf49gjkf0dFigura 7: Se evidencia una positividad de membrana en el componente sarcomatoide para CD-99, que es exclusivo de este tipo de carcinoma de mama.">
 fiogf49gjkf0dFigura 8: El marcador mioepitelial p63 es positivo en el componente de carcinoma ductal infiltrante.">
fiogf49gjkf0dFigura 8: El marcador mioepitelial p63 es positivo en el componente de carcinoma ductal infiltrante.">
 fiogf49gjkf0dFigura 9: La positividad para p63 es positivo en el componente sarcomatoide, mientras que aislada y débil en los cordones epiteliales.">
fiogf49gjkf0dFigura 9: La positividad para p63 es positivo en el componente sarcomatoide, mientras que aislada y débil en los cordones epiteliales.">